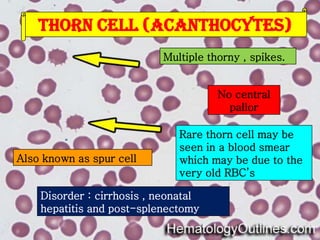
Thorn cell (acanthocytes)
Multiple thorny , spikes.

No central
pallor

Also known as spur cell

Rare thorn cell may be
seen in a blood smear
which may be due to the
very old RBC’s

Disorder : cirrhosis , neonatal
hepatitis and post-splenectomy
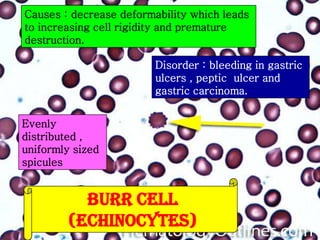
Causes : decrease deformability which leads
to increasing cell rigidity and premature
destruction.
Disorder : bleeding in gastric
ulcers , peptic ulcer and
gastric carcinoma.
Evenly
distributed ,
uniformly sized
spicules

BURR CELL
(ECHINOCYTES)
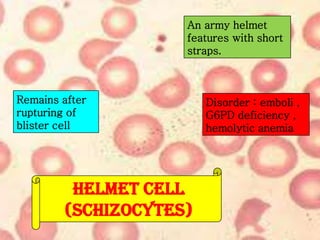
An army helmet
features with short
straps.

Remains after
rupturing of
blister cell

HELMET CELL
(SCHIZOCYTES)

Disorder : emboli ,
G6PD deficiency ,
hemolytic anemia
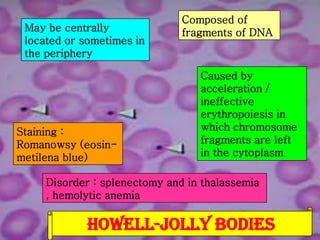
May be centrally
located or sometimes in
the periphery

Staining :
Romanowsy (eosinmetilena blue)

Composed of
fragments of DNA

Caused by
acceleration /
ineffective
erythropoiesis in
which chromosome
fragments are left
in the cytoplasm

Disorder : splenectomy and in thalassemia
, hemolytic anemia

HOWELL-JOLLY BODIES
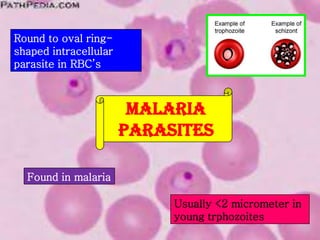
Round to oval ringshaped intracellular
parasite in RBC’s

MALARIA
PARASITES
Found in malaria
Usually <2 micrometer in
young trphozoites

This document provides information on various types of red blood cell morphologies seen on blood smears, including normal and abnormal shapes and inclusions. It describes normocytic and normochromic red blood cells as well as variations such as microcytic, macrocytic, poikilocytes (variations in shape), anisocytosis (variation in size), and polychromasia (variation in color). Specific abnormal red blood cells and inclusions are defined such as sickle cells, target cells, Howell-Jolly bodies, basophilic stippling, malaria parasites, and reticulocytes. Causes and disorders are provided for each abnormal finding.